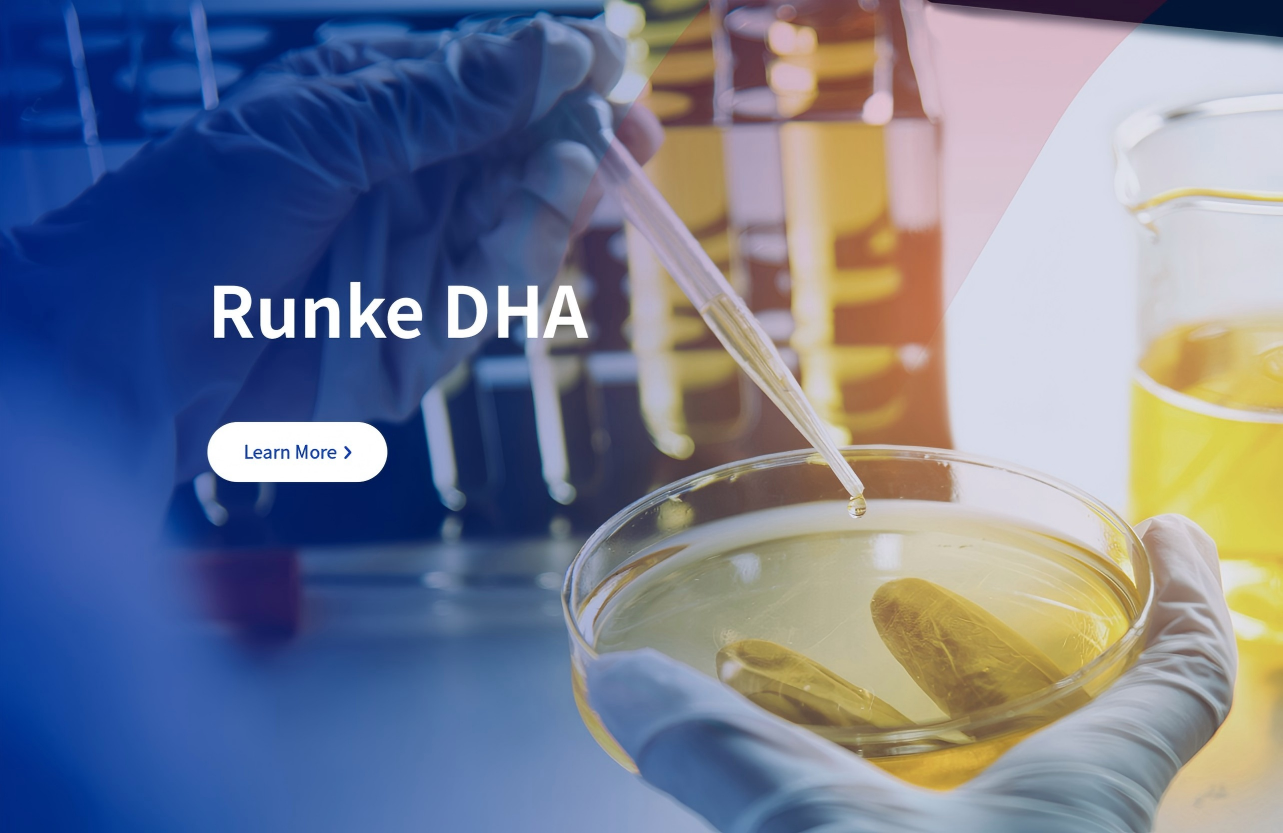
Runke Bioengineering New Official Website is Officially Launched

中文
EN

News Center
 Corporate News
Corporate News
Corporate Corporate News
Corporate News
News
2026-01-23
Safety Statement: No Bacillus cereus emetic toxin detected in Runke ARA and DHA products







View Details

2025-09-04
Runke Biology made an appearance at the South American FI South America exhibition!


View Details

2025-08-10
Runke Biology showcases microalgae technological innovation achievements at the first Shantou Health Expo


View Details

2025-06-27
Runke Biology makes an appearance at the 2025 Healthy Natural Raw Materials and Food Ingredients Exhibition, with microalgae technology empowering a new future for healthy food


View Details

2025-05-26
Runke Biology, together with its subsidiary Peizhi Biology, made an appearance at the 31st Annual Conference of the China Dairy Industry Association and the 2025 China Dairy Technology Expo.


View Details

2025-05-23
Runke Biology participated in the European Vitafoods exhibition with products such as DHA, ARA, Baodecong and compound nutrients.


View Details